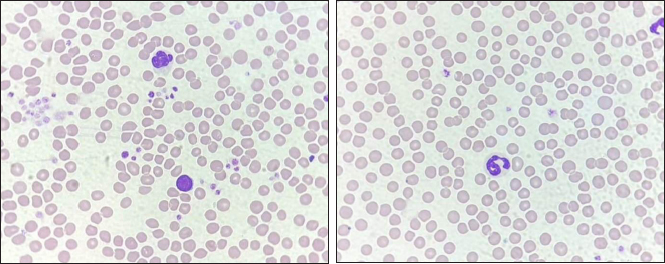

| Research Article | ||
Open Vet. J.. 2024; 14(5): 1199-1205 Open Veterinary Journal, (2024), Vol. 14(5): 1199–1205 Research Article Kanamycin treated-ethylenediamine tetraacetic acid-dependent pseudothrombocytopenia in blood specimen of catsNarissara Keawchana1, Pirayu Rakwong2 and Pratthana Yongsakulchai1*1Faculty of Veterinary Science, Prince of Songkla University, Songkhla, Thailand 2Hematology and Biochemistry Laboratory Unit, Veterinary Teaching Hospital, Faculty of Veterinary Science, Prince of Songkla University, Songkhla, Thailand *Corresponding Author: Pratthana Yongsakulchai. Faculty of Veterinary Science, Prince of Songkla University, Songkhla, Thailand. Email: pratthana.y [at] psu.ac.th Submitted: 12/02/2024 Accepted: 22/04/2024 Published: 31/05/2024 © 2024 Open Veterinary Journal
AbstractBackground: Pseudothrombocytopenia is a commonly obtained false negative result when analyzing feline platelet (PLT) count by an automated machine. It is related to ethylenediamine tetra-acetic acid (EDTA), a widely utilized anticoagulant in blood collection tubes, resulting in EDTA-dependent pseudothrombocytopenia (EDTA-PTCP). Aim: To investigate whether treated with kanamycin enhanced the quantity of PLT aggregations in feline blood specimens collected using EDTA-PTCP. Methods: Thirty-one blood samples were obtained using EDTA tubes. The complete blood count was analyzed using an automated Mindray BC-5000Vet. Both Manual cell counts and thin blood smears were performed to estimate the amount of red blood cell, white blood cell, and PLTs as well as to evaluate the severity scores of PLT clumping, respectively. Comparisons were made between those pre-treated and those treated with kanamycin in the EDTA tube. Results: There were significantly different mean PLT counts in the samples before and after they were treated with kanamycin, both on automated (156.6 ± 76.4 vs. 260.3 ± 115.5; p < 0.001) and manual (168.5 ± 92.1 vs. 262.8 ± 119.6; p < 0.001) readings, with a 95% confidence interval of 0.19 (0.022–0.365). Conclusion: This study suggests that in clinical laboratory practice, kanamycin should be added to feline blood specimens with EDTA-PTCP. Keywords: EDTA-PTCP, Feline, Kanamycin, Platelet clumping, Pseudothrombocytopenia. IntroductionEthylene diamine tetra-acetic acid (EDTA) serves as an anticoagulant by chelating calcium ions in blood specimens, facilitating its utilization in complete blood count (CBC) analyses. EDTA-dependent pseudothrombocytopenia (EDTA-PTCP), also known as EDTA-PTCP, is a laboratory occurrence characterized by an abnormally reduced platelet (PLT) count in samples carried in EDTA anticoagulation tubes. Subjects with EDTA-PTCP also do not show clinical signs of bleeding. This error may occur due to either enlarged PLTs or PLT clumping in the blood sample. The automated machine will categorize them as not PLTs, resulting in pseudothrombocytopenia. This phenomenon has been reported both in humans, with a prevalence of 0.04% (Nopparatara et al., 2001), and in veterinary fields (in cats, the prevalence of a PLT count < 200 × 109 cells/l was 3.1% (Norman et al., 2001). From June 2019 to May 2020, of the 1,463 feline hematology analysis reports at the Veterinary Teaching Hospital, Faculty of Veterinary Science, Prince of Songkla University, 527 cases had “PLTs clumping” detected. An adequate number of PLTs was found after these thin blood films were further analyzed for PLT estimation. These films were therefore reported as EDTA-PTCP. Previous reports have described introducing aminoglycosides such as kanamycin into blood collection tubes to prevent the reaction and dissociation of PLT clumping in human EDTA-PTCP samples (Sakurai et al., 1997; Chen et al., 2012) or amikacin in feline and canine EDTA-PTCP samples (Engelmann et al., 2022; Vasilatis et al., 2022). Some studies have pre-heated EDTA blood tubes before performing the PLT count (Williams and Archer, 2016). However, there is no report on the effect of kanamycin on feline EDTA-PTCP samples. Our focus in this research was to investigate whether the addition of affordable and readily available substances such as kanamycin to EDTA blood collection tubes improves the accuracy of automated PLT counts. Materials and MethodsBlood specimensVenipuncture blood retrieved from the cephalic veins of thirty cats. Each cat included in the study was over 1 year old, had a weight exceeding 3 kg, and had a body condition score ranging between 4 and 5 of 9 (ideal type) according to the guideline data sheet of the World Small Animal Veterinary Association in 2013 (Laflamme, 1997; Bjornvad et al., 2011). The animals recruited to the study exhibited normal behaviors and had no signs of depression, loss of appetite, unexplained weight loss, muscle weakness, and no clinical or biochemical signs of liver or kidney disease. Once the blood was added to the anticoagulation tube, it underwent a gentle inversion 5–10 times to ensure thorough mixing with the anticoagulant. Subsequently, the samples were then transported to the laboratory at room temperature (25oC), where immediate testing was conducted by the veterinary technician at the Hematology and Biochemistry Laboratory unit, Veterinary Teaching Hospital, Faculty of Veterinary Science, Prince of Songkla University. A total blood volume of 1 ml was divided into an EDTA tube (0.5 ml) for evaluating the CBC and PLT count, and a heparin tube (0.5 ml) for measuring liver and renal function. Each EDTA blood sample was separated into two 0.25 ml microcentrifuge tubes, with one designated for pre-treated and the other treated with 2.5 mg of kanamycin, followed by mixing using a vortex mixer. Before and after treated specimens were analyzed using the BC-5000Vet automated analyzer (Shenzhen Mindray Bio-Medical Electronics Co., Ltd. 2013). Manual blood counts were performed on a thin blood film with Wright–Giemsa stain. CBC and PLT countAutomated analyzerThe individual 0.25 ml of EDTA blood samples were loaded into an automated analyzer (model Mindray BC-5000Vet). The samples were analyzed by using flow cytometry for white blood cell (WBC) count and the electrical impedance method for red blood cell (RBC) and PLT counts. Results provided the values (unit) of CBC, including RBC count (10^6/µl), WBC count (10^3/µl), PLT count (10^6/µl), mean cell volume (MCV) (fL), mean cell hemoglobin (MCH) (pg), mean cell hemoglobin concentration (MCHC) (g/dl), RBC distribution width (RDW) (%), mean platelet volume (MPV) (fL), and platelet distribution width (PDW) (%). Manual blood counting methodAfter the EDTA blood sample had been analyzed by the automated machine, the residue was used for manual blood cell counting. The manual RBC count method involved diluting the sample with an isotonic RBC counting solution in 1:200 dilution before evaluation by a hemocytometer. The RBC counting result was reported as the number of RBCs per cubic milliliter (mm3). WBC counting was performed by diluting the blood with Turk’s solution, which lyses RBCs which preserving WBC integrity. The diluted samples were eventually used to calculate the total WBC count per mm3. PLT counting was performed using the Brecher–Cronkite method, which involves diluting blood with a 1% ammonium oxalate solution. This solution induces lysis of RBCs while maintaining the integrity of WBCs and PLTs. Afterward, the number of cells for each cell type was determined using a hemocytometer, and the results were adjusted according to the dilution factor. PLT number was reported as number of total PLTs per microliter (µl). Table 1. The comparison of CBC data between pre-treated and treated with kanamycin which derived from automated machine and manual counts.
Fig. 1. The measurement methods by using the automated machine and manual cell counts to estimate the effects of kanamycin on the PLT numbers (103/μl). (*): Significance difference p < 0.05.
Fig. 2. The dispersion of PLTs of pre-treated (A) and treated with kanamycin (B) (10×). Thin blood smear and Wright–Giemsa stainingThe EDTA blood residue from the above procedures was dropped on a glass slide. Another slide was placed above the drop until the blood spread along its edge. The slide was then pushed toward the other side quickly then allowed to dry. A small amount of Wright–Giemsa stain was placed on the thin blood smear, before flooding it with buffer solution and mixing them together with a rubber ball. The slide was rinsed with distilled water after 5 minutes, or when a metallic sheen appeared. The blood cells were then examined under a light microscope. Images of the blood smears both pre-treated and treated with kanamycin were captured to compare blood staining, morphology, distribution, and arrangement. If abnormal blood characterization was visualized on the blood smear, such as RBC rouleaux formation or agglutination, leukocyte aggregation, or PLT aggregation, it was reported. Kanamycin (10 mg per ml) was added to the blood samples and all the above procedures were repeated, then reported as “treated with kanamycin” results.
Fig. 3. The staining of RBCs and WBCs of pre-treated (A) and treated (B) with kanamycin (40×). Severity scores of PLT clumpingWe divided the cats into groups based on their PLT counts before and after their samples were treated with kanamycin: these groups were low (< 100 × 103/µl); normal (100–518 × 103/µl); and high (> 518 × 103/µl). The PLT estimation from the standard area of the thin blood film was also used to split the samples into three groups including < 5 cells/oil power field (OPF) as decreased; 5–25 cells/OPF as adequate; and >25 cells/OPF as increased. Then, the manifestation of PLT clumping on the standard area of thin blood smear enabled severity scoring as previously described (Tvedten et al., 2015). Briefly, both of the number and sizes of PLT clumping derived from five fields of the standard area (100× oil objective) were observed: if no PLT clumping was observed, the sample was classed as grade 0; if <2 had some small clumping, it was grade 1+; if 2–5 fields had small or <2 fields had large clumping, it was grade 2+; if 2–5 fields had large clumping, it was grade 3+; and if > 5 had large clumping, it was classed as grade 4+. The examination also included evaluating both the numbers and sizes of PLT clumping at the feathered edge using a 100× oil objective. The grading system as follows: no appearance of PLT aggregate, it was classed as grade 0; if there were <5 small aggregates, it was grade 1+; if there were >5 small aggregates or 1–2 large aggregates, it was grade 2+; if there were 3–10 large aggregates, it was grade 3+; and fields with >10 large aggregates were classed as grade 4+. When large PLT aggregates were presented, the significance of the number of small-sized aggregates diminished. Liver and renal function testsThe tests were performed by using plasma from the 0.5 ml heparin tube. Plasma was loaded and analyzed by the automated Mindray BS120 machine. The liver and renal profiles including alanine transaminase (ALT) (U/l), alkaline phosphatase (ALP) (U/l), blood urea nitrogen (BUN) (mg/dl), and creatinine (mg/dl) were assessed by absorbance photometry principle. Criteria for normal liver enzymes were ALT 25–97 U/l and ALP(0–45 U/l). For renal profiles, normal values were BUN 19–34 mg/dl, and creatinine 0.9–2.2 mg/dl (Latimer, 2011). Statistical analysisStatistical calculation was performed using Minitab (LLC, 2021. Minitab, Available at: http://www.minitab.com). The Anderson–Darling test was accomplished to conduct the normality test of the quantitative data for complete blood parameters including RBC count, WBC count, PLT count, MCV, MCH, MCHC, RDW, MPV, and PDW. The data were presented as mean and standard deviation (mean ± SD) if they exhibited a normal distribution. For data that did not follow a normal distribution, they were demonstrated as median (minimum, maximum). For normally distributed data, the means of variables before and after adding kanamycin were compared using the Paired t-test. The Wilcoxon signed-rank test was applied to compare the median values pre-treated and treated with kanamycin for the data that was not normally distributed. For dependent categorical data, the frequency was calculated and compared using the McNemar test and Friedman test. The statistically significant difference was accepted when the p-value was less than 0.05. Additionally, blood cell staining, blood cell morphology, blood cell arrangement, and PLT aggregation were evaluated by comparing the images captured pre-treated and treated with kanamycin. Ethical approvalThe procedure was conducted after ethics was approved by the Ethics Committee of Prince of Songkla University Animal Standard, Prince of Songkla University, Hat Yai, Songkhla, Thailand. The approval number is 2564-05-006. ResultsOf all thirty-one cats (19 females, 12 males), the mean age was 3.04 ± 1.56 years and their mean weight was 4.40 ± 0.96 kg. Liver and renal profiles were within normal limits. The means ± SDs of biochemical profiles were as follows: ALT 57.97 ± 19.75 U/l; ALP 27.17 ± 10.17 U/l; BUN 23.01 ± 5.31 mg/dl; and creatinine 1.23 ± 0.34 mg/dl. All the CBCs from automated and manual assessments except for RDW and PDW from the automated method, and RBC from both methods, were normally distributed. Either the mean ± SD or median (min, max) of the CBCs of those pre-treated and treated with kanamycin both from the automated and manual methods were exhibited in Table 1. We found that the overall means of PLT count were significantly increased on both automated and manual methods of assessment when treated with kanamycin (p < 0.001) (Fig. 1). Most samples (n=23) had increased numbers of PLTs to within the normal range. Six of the 31 cats moved a level up, from low to normal levels. Two of the cats were truly thrombocytopenia. The odds ratio of both methods was equal at 0.194, with a 95% confidence interval (95% CI) of between 0.022 and 0.365 (p=0.031). However, the other RBC-associated parameters from the automated method were also significantly elevated, including RBC, MCV, MCH, MCHC, and RDW. However, the manual RBC and WBC counts were not significantly different between the groups. For PLT estimation, one cat had missing data. None of the cats had an abnormally high number of PLTs. The PLT estimation from the standard area of the thin blood film had shown 26 cats had improved the number of PLT cells/OPF, despite they were within the same degree as previously. Four cats (13.33%) had remained in the decreased degree of PLT estimation. The other 22 cats (73.33%) had changed within adequate levels. Four samples (13.33%) were PLT clumping effectively dispersed after being treated with kanamycin, then, the number of PLTs increased to the adequate level (p=0.125). The severity score of PLTs clumping at the standard area was categorized as 0 (n=1, 3.23%), 1+ (n=3, 9.68%), 3+ (n=7, 22.58%), and 4+ (n=20, 64.52%). Their overall scores after being treated with kanamycin were decreased to 0 (n=3, 9.68%), 1+ (n=1, 3.23%), 2+ (n =1, 3.23%), 3+ (n 8, 25.81%), and 4+ (n=18, 58.06%) (adjusted p=0.157). The PLTs clumped at the feathered edge of the smear were more evenly distributed, reducing the aggregation of PLTs. The severity scores were 0 (n=11, 35.48%), 1+ (n=10, 32.26%), and 2+ (n=10, 32.26%). The severity scores after being treated with kanamycin were 0 (n=23, 74.19%), 1+ (n=7, 22.58%), and 2+ (n=1, 3.23%) (adjusted p < 0.001). The schematic of PLT aggregation in the feather edge area is represented in Figure 2. Microscopically, the blood smears revealed no morphological changes in the RBCs, WBCs, or PLTs after being treated with kanamycin (Fig. 3). However, due to the acidity of kanamycin, there was a slight increase in the intensity of staining for RBCs. DiscussionEDTA is normally used as an anticoagulating agent in blood collection tubes to evaluate RBC, WBC, and PLT profiles. However, it can also induce PLT aggregation in blood samples. The mechanism of EDTA-PTCP in human blood samples was initially described by Gowland et al. (1969). It is attributed to the agglutination of anti-PLT antibodies including immunoglobulin G, immunoglobulin M, and immunoglobulin A, through reactions with antigens on PLT surfaces (Onder et al., 1980). However, in humans, these antigens react with PLTs obtained from normal individuals but do not exhibit reactivity with PLTs derived from Glanzmann disease patients (Pegels et al., 1982). In thirty-three patients with pseudothrombocytopenia, the PLT agglutination in EDTA samples was prevented by antigens to the glycoprotein αIIbβ3 monoclonal antibodies on activated PLTs (Casonato et al., 1994). This suggests that EDTA induces PLT aggregation and clumping by attaching to the glycoprotein αIIbβ3 receptors, then activating several proteins such as Granular Membrane Protein (GMP-140) or P-selectin, Gp55 (CD63), and thrombospondin, following by stimulation and expression of the tyrosine kinase pathway (Lippi and Plebani, 2012). In veterinary medicine, true thrombocytopenia in cats is rare but automated low PLT counts are common in laboratory reports (Chen et al., 2012). The distinctive characteristics of feline PLTs such as larger size that results in a higher concentration of serotonin (Peterson et al., 1995) enable quicker reactions to be induced using lower concentrations of adenosine diphosphate (MacMillan and Sim, 1970). Additionally, their large sizes are likely to be mistaken for RBCs and then excluded on automated PLT cell counts. Moreover, the small size and non-compliant nature of feline blood vessels make it challenging to collect blood samples, increasing the likelihood of PLT clumping in vitro. These aggregations of PLTs are counted as one large cell in automated PLT count analyzers. The studies on the use of another aminoglycoside include gentamicin, streptomycin, etimicin, amikacin, and kanamycin. There were only amikacin and kanamycin were conducted on preventing and inhibiting PLT clumping in patients with EDTA-PTCP (Chen et al., 2012). Especially amikacin, when incubated with blood samples and compared to immediately processed samples using an automated blood analyzer and thin blood film preparation. The results showed that the use of amikacin generally resulted in higher relative indices compared to the immediate processing group (Sakurai et al., 1997; Zhou et al., 2011; Konstantinidou et al., 2017; Engelmann et al., 2022). While, in this study, we also found that the use of 10 mg/ml of kanamycin improved the number of PLTs with a 95% CI of 0.19 (0.022–0.365) and a p-value of 0.031. Amikacin and kanamycin might be the blockers of CD61-FITC (FIB-R) or inhibitors of the clotting factors (Chen et al., 2012). In conclusion for routine laboratory investigations, we recommend that the RBC and/or WBC counts should be performed before filling kanamycin to the sample, in order not to alter the number of CBC and WBC counts. After adding kanamycin, then the PLT number and thin blood smear should be evaluated. Kanamycin did not result in any distinct changes in the morphology of blood cells when examined under a microscope using thin blood film preparation. AcknowledgmentsThis research was granted by the Faculty of Veterinary Science, Prince of Songkla University, Thailand. The authors would like to appreciate the kind support from Thanittha Techaniyom for the statistics consultation. And we would like to thank all cat owners for their cooperation. Conflict of interestThe authors declare that there is no conflict of interest. FundingThe project was funded by the Faculty of Veterinary Science, Prince of Songkla University, Songkhla, Thailand. Authors’ contributionsNarissara Keawchana and Pirayu Rakwong contributed to the study design, and animal ethic approval, recruited subjects, manipulated blood examination, and wrote the manuscript draft. Pirayu Rakwong and Pratthana Yongsakulchai oversaw the animal restraint and venipuncture. Pratthana Yongsakulchai, the corresponding author was responsible for giving counsel on the study design and the manuscript, analyzing the statistics, and approving the manuscript. All authors have read and agreed to the published version of the manuscript. Data availabilityAll data supporting the findings of this study are available within the manuscript. ReferencesBjornvad, C.R., Nielsen, D.H., Armstrong, P.J., McEvoy, F., Hoelmkjaer, K.M., Jensen, K.S., Pedersen, G.F. and Kristensen, A.T. 2011. Evaluation of a nine-point body condition scoring system in physically inactive pet cats. Am. J. Vet. Res. 72(4), 433–437. Casonato, A., Bertomoro, A., Pontara, E., Dannhauser, D., Lazzaro, A.R. and Girolami, A. 1994. EDTA dependent pseudothrombocytopenia caused by antibodies against the cytoadhesive receptor of platelet gpIIB-IIIA. J. Clin. Pathol. 47, 625–630. Chen, G., Fei, X. and Ling, J. 2012. The effects of aminoglycoside antibiotics on platelet aggregation and blood coagulation. Clin. Appl. Thromb. Hemost. 18(5), 538–541. Engelmann, A.M., Veleda, P.A., Mello, C.B.E., Dutra, L.S., Mann, T.R., Bueno, A., Krause, A. and Andrade, C.M. 2022. Amikacin prevents platelet aggregation in feline venous blood samples. Vet. Clin. Pathol. 51(2), 51–56. Gowland, E., Kay, H.E., Spillman, J.C. and Williamson, J.R. 1969. Agglutination of platelets by a serum factor in the presence of EDTA. J. Clin. Pathol. 22(4), 460–464. Konstantinidou, V., Vagdatili, E., Eleftheriou, F. and Tsikopoulos, A. 2017. Reversal of platelet aggregation by supplementation with amikacin in vitro. Arch. Hellenic. Med. 34(10), 86–90. Laflamme, D.P. 1997. Development and validation of a body condition score system for cats: a clinical tool. Feline Pract. 25, 13–18. Latimer, K.S. 2011. Duncan & Prasse’s veterinary laboratory medicine: clinical pathology, 5th ed. Hoboken, NJ: Willey-Blackwell, pp: 509. Lippi, G. and Plebani, M. 2012. EDTA-dependent pseudothrombocytopenia: further insights and recommendations for prevention of a clinically threatening artifact. Clin. Chem. Lab. Med. 50(8), 1281–1285. MacMillan, D.C. and Sim, A.K. 1970. A comparative study of platelet aggregation in man and laboratory animals. Thromb. Diath. Haemorrh. 24, 385–394. Nopparatana, C., Chawakul, D. and Nakkarabundit, N. 2015. Prevalence and problem-solving method of EDTA-dependent pseudothrombocytopenia at Songklanagarind hospital. Songkla. Med. J. 33(6), 293–303. Norman, E.J., Barron, R.C.J., Nash, A.S. and Clampitt, R.B. 2001. Prevalence of low automated platelet counts in cats: comparison with prevalence of thrombocytopenia based on blood smear estimation. Vet. Clin. Pathol. 30(3),137–140. Onder, O., Weinstein, A. and Hoyer, L.W. 1980. Pseudothrombocytopenia caused by platelet agglutinins that are reactive in blood anticoagulated with chelating agents. Blood. 56(2), 177–182. Pegels, J.G., Bruynes, E.C., Engelfriet, C.P. and von dem Borne, A.E. 1982. Pseudothrombocytopenia: an immunologic study on platelet antibodies dependent on ethylene diamine tetra-acetate. Blood 59(1), 157–161. Peterson, J.L., Couto, C.G. and Wellman, M.L. 1995. Hemostatic disorders in cats: a retrospective study and review of the literature. J. Vet. Intern. Med. 9, 298–303. Sakurai, S., Shiojima, I., Tanigawa, T. and Nakahara, K. 1997. Aminoglycosides prevent and dissociate the aggregation of platelets in patients with EDTA-dependent pseudothrombocytopenia. Br. J. Haematol. 99(4), 817–823. Tvedten, H.W., Backlund, K. and Lilliehook, I.E. 2015. Reducing error in feline platelet enumeration by addition of Iloprost to blood specimens: comparison to prostaglandin E1 and EDTA. Vet. Clin. Pathol. 4(2), 179–187. Vasilatis, D.M., Walker, N. and Borjesson, D.L. 2022. Amikacin disaggregates platelet clumps in EDTA blood samples from cats and dogs when added postcollection. Vet. Clin. Path. 52, 228–235. Williams, T. and Archer, J. 2016. Effect of prewarming EDTA blood samples to 37°C on platelet count measured by Sysmex XT-2000iV in dogs, cats, and horses. Vet. Clin. Pathol. 45(3), 444–449. Zhou, X., Wu, X., Deng, W., Li, J. and Luo, W. 2011. Amikacin can be added to blood to reduce the fall in platelet count. Am. J. Clin. Pathol. 136(4), 86–90. | ||
| How to Cite this Article |
| Pubmed Style Keawchana N, Rakwong P, Yongsakulchai P. Kanamycin treated-ethylenediamine tetraacetic acid (EDTA)-dependent pseudothrombocytopenia in blood specimen of cats. Open Vet. J.. 2024; 14(5): 1199-1205. doi:10.5455/OVJ.2024.v14.i5.15 Web Style Keawchana N, Rakwong P, Yongsakulchai P. Kanamycin treated-ethylenediamine tetraacetic acid (EDTA)-dependent pseudothrombocytopenia in blood specimen of cats. https://www.openveterinaryjournal.com/?mno=186106 [Access: January 25, 2026]. doi:10.5455/OVJ.2024.v14.i5.15 AMA (American Medical Association) Style Keawchana N, Rakwong P, Yongsakulchai P. Kanamycin treated-ethylenediamine tetraacetic acid (EDTA)-dependent pseudothrombocytopenia in blood specimen of cats. Open Vet. J.. 2024; 14(5): 1199-1205. doi:10.5455/OVJ.2024.v14.i5.15 Vancouver/ICMJE Style Keawchana N, Rakwong P, Yongsakulchai P. Kanamycin treated-ethylenediamine tetraacetic acid (EDTA)-dependent pseudothrombocytopenia in blood specimen of cats. Open Vet. J.. (2024), [cited January 25, 2026]; 14(5): 1199-1205. doi:10.5455/OVJ.2024.v14.i5.15 Harvard Style Keawchana, N., Rakwong, . P. & Yongsakulchai, . P. (2024) Kanamycin treated-ethylenediamine tetraacetic acid (EDTA)-dependent pseudothrombocytopenia in blood specimen of cats. Open Vet. J., 14 (5), 1199-1205. doi:10.5455/OVJ.2024.v14.i5.15 Turabian Style Keawchana, Narissara, Pirayu Rakwong, and Pratthana Yongsakulchai. 2024. Kanamycin treated-ethylenediamine tetraacetic acid (EDTA)-dependent pseudothrombocytopenia in blood specimen of cats. Open Veterinary Journal, 14 (5), 1199-1205. doi:10.5455/OVJ.2024.v14.i5.15 Chicago Style Keawchana, Narissara, Pirayu Rakwong, and Pratthana Yongsakulchai. "Kanamycin treated-ethylenediamine tetraacetic acid (EDTA)-dependent pseudothrombocytopenia in blood specimen of cats." Open Veterinary Journal 14 (2024), 1199-1205. doi:10.5455/OVJ.2024.v14.i5.15 MLA (The Modern Language Association) Style Keawchana, Narissara, Pirayu Rakwong, and Pratthana Yongsakulchai. "Kanamycin treated-ethylenediamine tetraacetic acid (EDTA)-dependent pseudothrombocytopenia in blood specimen of cats." Open Veterinary Journal 14.5 (2024), 1199-1205. Print. doi:10.5455/OVJ.2024.v14.i5.15 APA (American Psychological Association) Style Keawchana, N., Rakwong, . P. & Yongsakulchai, . P. (2024) Kanamycin treated-ethylenediamine tetraacetic acid (EDTA)-dependent pseudothrombocytopenia in blood specimen of cats. Open Veterinary Journal, 14 (5), 1199-1205. doi:10.5455/OVJ.2024.v14.i5.15 |